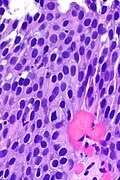

Difference between revisions of "Urothelial dysplasia"
Jump to navigation
Jump to search
(→IHC) |
(→IHC) |
||
| Line 98: | Line 98: | ||
*Morphology is considered the gold standard for UCIS versus urothelial dysplasia;{{fact}} however, there is a small literature on IHC for dysplasia versus UCIS | *Morphology is considered the gold standard for UCIS versus urothelial dysplasia;{{fact}} however, there is a small literature on IHC for dysplasia versus UCIS that is published in lesser known journals and suggests:<ref name=pmid19690775>{{Cite journal | last1 = Stepan | first1 = A. | last2 = Mărgăritescu | first2 = C. | last3 = Simionescu | first3 = C. | last4 = Ciurea | first4 = R. | title = E-cadherin and p63 immunoexpression in dysplastic lesions and urothelial carcinomas of the bladder. | journal = Rom J Morphol Embryol | volume = 50 | issue = 3 | pages = 461-5 | month = | year = 2009 | doi = | PMID = 19690775 }}</ref><ref>{{Cite journal | last1 = Raheem| first1 = Sayad A.| last2 = Saied | first2 = Abdel N. | last3 = Al Shaer | first3 = Rabee | last4 = Mustafa | first4 = Osama | last5 = Ali | first5 = Ali H. | title = The Role of CK20, p53 and p63 in Differentiation of Some Urothelial Lesions of Urinary Bladder, Immunohistochemical Study | journal = [http://www.scirp.org/journal/ojpathology Open Journal of Pathology] | volume = | issue = 4| pages = 181-193 | month = | year = 2014 | doi = 10.4236/ojpathology.2014.44024 | PMID = | PMC = | url = }}</ref> | ||
*p63 -ve at surface in dysplasia. | *p63 -ve at surface in dysplasia. | ||
**p63 +ve at surface in UCIS | **p63 +ve at surface in UCIS | ||
Revision as of 12:14, 18 May 2016
| Urothelial dysplasia | |
|---|---|
| Diagnosis in short | |
 Urothelial dysplasia. H&E stain. | |
|
| |
| Synonyms | low-grade urothelial dysplasia |
|
| |
| LM | mild nuclear enlargement (~3x a resting lymphocyte) and hyperchromasia, mild disorganization of the architecture (some maturation), occasional mitotic figures - none atypical |
| LM DDx | reactive changes, urothelial atypia of unknown significance, urothelial carcinoma in situ |
| IHC | CK20 +ve/-ve (esp. non-umbrella cells), Ki-67 +ve/-ve (>10%), p53 +ve/-ve (>20%) |
| Site | urothelium (renal pelvis, urinary bladder, ureters, urethra) |
|
| |
| Prevalence | common |
| Prognosis | pre-malignant |
Urothelial dysplasia, also low-grade (urothelial) dysplasia, is a lesion of the urothelium in the ISUP/WHO 2004 classification.[1]
It is precursor lesion to urothelial carcinoma that is less worrisome than urothelial carcinoma in situ (also known as high-grade (urothelial) dysplasia).
General
The ISUP/WHO classification of flat urothelial lesions is:[1]
- Reactive urothelial atypia.
- Flat urothelial hyperplasia.
- Urothelial atypia of unknown significance.
- Urothelial dysplasia (low-grade dysplasia).
- Urothelial carcinoma in situ (high-grade dysplasia).
- Invasive urothelial carcinoma.
Microscopic
Features:[2]
- Mild nuclear enlargement (~3x a resting lymphocyte) and hyperchromasia.
- Slight disorganization of the architecture.
- Some maturation to the surface - important.
- Mitotic figures - occasional, none atypical.
Notes:
- It is probably not a good idea to make this diagnosis without immunohistochemistry.
- This diagnosis not made on frozen section.
DDx:
- Benign urothelium with reactive changes.
- Urothelial carcinoma in situ - no maturation to the surface or marked atypia - as in pagetoid UCIS and undermining UCIS.[3]
Images
www:
IHC
A comparison between benign, dysplasia and UCIS:[4]
| Diagnosis | CK20 | Ki-67 | p53 |
|---|---|---|---|
| Benign (reactive) | umbrella cells +ve only | -ve <=10% of cells (+/-rare basal cells) | -ve <20% of cells (+/-weak staining) |
| Urothelial dysplasia | +ve non-umbrella cells +ve (~30% of cases) | +ve >10% of cells (~40% of cases) | +ve >=20% of cells (~70% of cases) |
| Urothelial carcinoma in situ (UCIS | +ve non-umbrella cells (~70% of cases) | +ve >10% of cells (~95% of cases) | +ve >=20% of cells (~80% of cases) |
- Morphology is considered the gold standard for UCIS versus urothelial dysplasia;[citation needed] however, there is a small literature on IHC for dysplasia versus UCIS that is published in lesser known journals and suggests:[5][6]
- p63 -ve at surface in dysplasia.
- p63 +ve at surface in UCIS
Sign out
A. RIGHT URETER (MARGIN), EXCISION: - UROTHELIAL DYSPLASIA, SEE COMMENT. - NEGATIVE FOR UROTHELIAL CARCINOMA. COMMENT: There is focal non-umbrella cell CK20 staining, 10% (focal) urothelial p53 staining, and 30% (focal) urothelial Ki-67 staining. The findings are that of (low-grade) urothelial dysplasia.
See also
References
- ↑ 1.0 1.1 Hodges, KB.; Lopez-Beltran, A.; Davidson, DD.; Montironi, R.; Cheng, L. (Feb 2010). "Urothelial dysplasia and other flat lesions of the urinary bladder: clinicopathologic and molecular features.". Hum Pathol 41 (2): 155-62. doi:10.1016/j.humpath.2009.07.002. PMID 19762067.
- ↑ URL: http://pathology.jhu.edu/bladder/image1.cfm?case_number=10&image_number=1. Accessed on: 31 December 2013.
- ↑ McKenney, JK.; Gomez, JA.; Desai, S.; Lee, MW.; Amin, MB. (Mar 2001). "Morphologic expressions of urothelial carcinoma in situ: a detailed evaluation of its histologic patterns with emphasis on carcinoma in situ with microinvasion.". Am J Surg Pathol 25 (3): 356-62. PMID 11224606.
- ↑ Mallofré, C.; Castillo, M.; Morente, V.; Solé, M. (Mar 2003). "Immunohistochemical expression of CK20, p53, and Ki-67 as objective markers of urothelial dysplasia.". Mod Pathol 16 (3): 187-91. doi:10.1097/01.MP.0000056628.38714.5D. PMID 12640096.
- ↑ Stepan, A.; Mărgăritescu, C.; Simionescu, C.; Ciurea, R. (2009). "E-cadherin and p63 immunoexpression in dysplastic lesions and urothelial carcinomas of the bladder.". Rom J Morphol Embryol 50 (3): 461-5. PMID 19690775.
- ↑ Raheem, Sayad A.; Saied, Abdel N.; Al Shaer, Rabee; Mustafa, Osama; Ali, Ali H. (2014). "The Role of CK20, p53 and p63 in Differentiation of Some Urothelial Lesions of Urinary Bladder, Immunohistochemical Study". Open Journal of Pathology (4): 181-193. doi:10.4236/ojpathology.2014.44024.